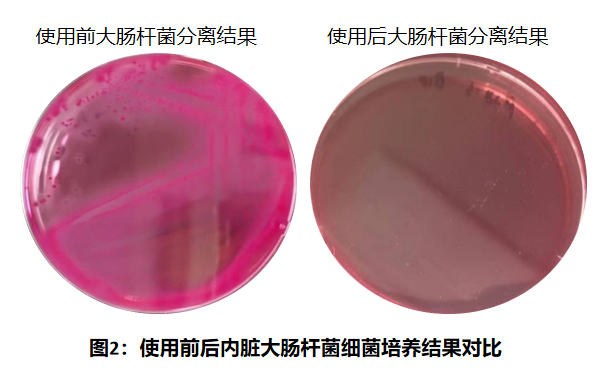
image.png

发布时间:2023-10-30 15:56:54 浏览次数:761次

案例1:之微方案3天解决鹌鹑腹膜炎顽疾
一、案例描述
浙江某鹌鹑养殖场养殖鹌鹑10万羽,持续散发腹泻,部分采食不佳,导致禽群消瘦,有较大死亡,持续每日死亡率达到4‰,产蛋量大幅下降。养殖场老板按照自己的经验连续使用多种西药中药,用药3个月后出现病情反复,每天死亡数量仍再上升,如果持续下去将带来严重的经济损失。公司技术指导老师观察现场后发现病死鹌鹑腹部青紫,闭目发呆,羽毛松乱,怀疑可能存在大肠杆菌感染,连续多月使用抗生素可能已经导致耐药菌株出现的情况,当即带回发病鹌鹑,经解剖病检发现显著腹膜炎,心包炎症状明显。进一步病原菌分离鉴定确定为大肠杆菌感染。
二、之微综合方案
1、改善现场环境,清扫残留粪便,调整舍内温度和通风,环境消毒等
2、噬菌体靶向净化1疗程
3、提高动物体免疫力和抗病能力
三、效果反馈
3.1 之微方案显著降低死淘率、提升产蛋率
方案实施期间每天观察并记录各舍的死淘情况,产蛋率和产蛋质量;及时对病死鹌鹑进行解检,采样及病原检测。跟踪对比使用后一周的整体死淘率,日均产蛋率和坏蛋率。
表1:使用期间及使用后(一周)数据统计跟踪
日期 | 出蛋量 | 白蛋率 | 死亡数 |
使用第1天 | 1900斤(77框) | 5‰ | 400只 |
使用第2天 | 1975斤(79框) | 5‰ | 420只 |
使用第3天 | 2050斤(82框) | 4.6‰ | 350只 |
使用后第1天 | 2025斤(81框) | 4.3‰ | 300只 |
使用后第2天 | 2025斤(81框) | 4‰ | 200只 |
使用后第3天 | 2025斤(81框) | 3.5‰ | 120只 |
使用后第4天 | 2025 斤(81 框) | 3‰ | 70只 |
3.2 3天时间使用后内脏大肠杆菌检测由阳转阴

使用微噬系列产品前采集病淘样品取内脏组织核酸检测到大肠杆菌强阳性,使用微噬系列产品期间跟踪检测病淘样品中大肠杆菌情况,使用3天后检测大肠杆菌阴性(如图1所示)。使用前从内脏中分离到显著大肠杆菌菌落,使用后未分离到大肠杆菌(如图2所示)。

下一条:给我一分信任,还您一份满意!

服务热线(期待您的来电):

地址:湖北省武汉市江夏区郑店街道光谷南大健康产业园30号

邮箱:HBZW_Chenzaiwei@163.com
扫一扫关注我们
